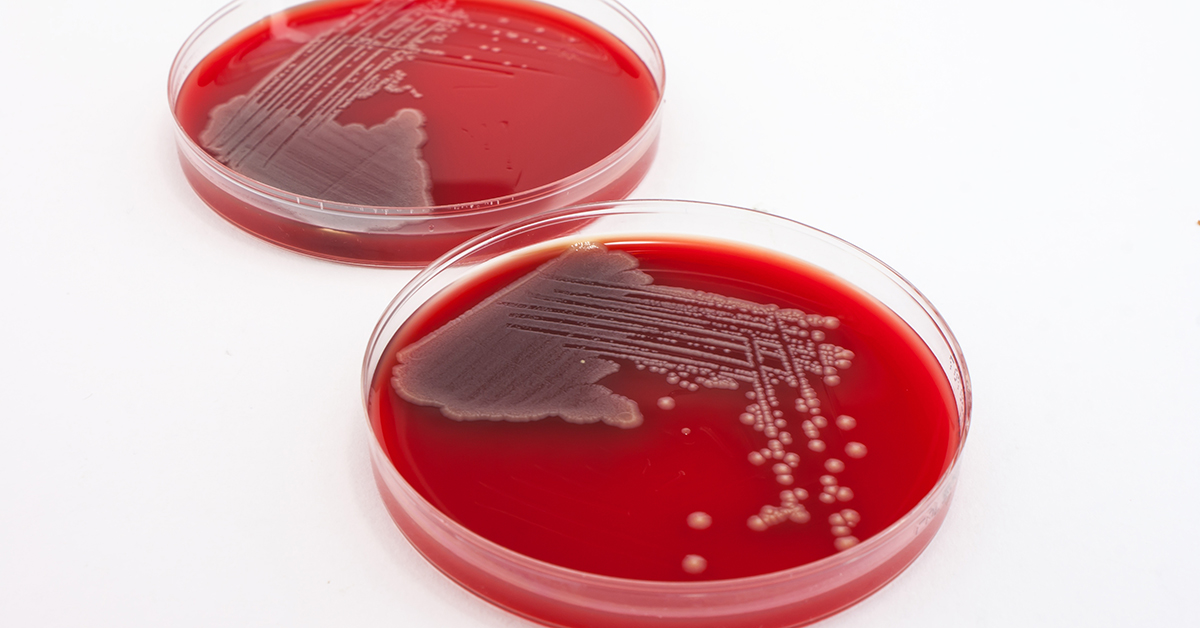
E.coli growth in agar plates

Effective control of pathogenic microorganisms in production
20 January 2026 | Suzanne Jordan, Molecular Microbiology and Methods Section Lead, and Linda Everis, Microbiological Safety and Spoilage Section Lead
The UK Health Security Agency have reported that both Campylobacter and Salmonella cases in England have shown a 17.1% increase from 2023 to 2024, with cases of both at their highest in a decade. According to The European Union One Health 2024 Zoonoses Report, the overall number of foodborne illness outbreaks in 2024 increased 14.5% compared to 2023. Cultured-confirmed cases of Shiga toxin-producing Escherichia coli (STEC) reported in England were up 26.1% in 2024 compared to 2023. And the period from 2010 to 2024 saw 13 cases of foodborne botulism in the UK.
For all foodborne pathogens, controlling their presence throughout the supply chain is as important as ever.
Within our food system, there are a number of drivers for outbreaks of pathogens of well-established concern, as well as the emergence of new / emerging pathogens. Which pathogens may present a risk in foods will depend on how the food is grown, harvested, handled, processed and packaged – we have another blog on which food types are prone to which pathogens and why.
Here, we explore some of the ways that we can help when it comes to pathogens, including general control, pathogen typing, inoculated studies with Clostridium botulinum, and STEC testing.
Across our microbiology, food safety and other expertise, we provide comprehensive, holistic support with the food safety assurance of your end-to-end supply chain, including effective control of pathogen strains in production.
Pathogen typing – trace the source of contamination
The identification and characterisation of microorganisms is a key part of the management of food safety and quality, tracing contaminants and troubleshooting problems such as spoilage or the presence of a pathogen in your product.
Whether dealing with consumer complaints or a microbial contamination issue identified internally (e.g. unexpected presence of microorganisms found in routine testing), understanding and addressing the source and cause are top priorities when such issues occur.
Many microorganisms occupy a diverse range of habitats, so the only way of knowing the origins of a particular contaminant is to identify / characterise each isolate to enable more in-depth analysis. Typing methods generate profiles which can be compared to assess similarity of strains isolated from products as well as the environment or particular food ingredient.
As such, typing the microorganism present in a sample can help to understand the contamination occurring within a factory or product components, as well as highlighting potential sources of product contamination. Whether investigating the presence of microorganisms in product samples or in environmental monitoring samples, this level of understanding enables further investigation and targeted preventative / corrective actions so that you can fully address the issue and prevent reoccurrence.
We can help companies with microbial contamination issues by identifying or typing the organism involved. Alongside fast, accurate, reliable results, our experts can also support you with interpretation to help troubleshoot the source and cause of the contamination.
Through next generation sequencing, we will soon be able to offer genotyping for Salmonella and Listeria.
Clostridium botulinum – inoculated studies including toxin testing
Clostridium botulinum (C.botulinum) is a pathogenic, anaerobic bacterium that can form heat-resistant spores. pH, salt and water activity levels all affect whether or not it can grow in foods and ultimately produce its toxin and pose a risk.
The UK Food Standards Agency (FSA) have issued specific guidance (published December 2020) on shelf-life requirements for low oxygen modified atmosphere packed (MAP) and vacuum packed (VP) products. This guidance recommends a limited shelf-life (a maximum of 10 days), unless particular parameters of pH, water activity, salt or thermal process are used. A shelf-life of greater than 10 days can be applied if it can be proven by predictive modelling or inoculated challenge test studies that non-proteolytic C.botulinum will not grow.
We have the capability to work with C.botulinum in our dedicated C.botulinum laboratory.
We can carry out inoculated microbiological growth challenge testing studies looking at growth of the organism in a range of food products over shelf-life. This is of particular benefit if a product does not meet any of the controlling factors given in the FSA 2020 guidance for non-proteolytic C.botulinum in VP / MAP chilled products requiring a shelf-life of greater than 10 days.
We have also developed an in-house method to allow us to analyse samples for the presence of toxin, which is also mentioned in the FSA guidance.
We also carry out microbiological growth challenge testing studies with proteolytic C.botulinum. This is of benefit for ambient stable products with a pH greater than 4.5 that may not have received a full sterilisation process. We can also test for the presence of Toxin A and B in these samples.
Alongside these growth studies we can carry out thermal inactivation challenge studies (microbiological process inactivation potential challenge tests) to validate a process with respect to the log reduction of C.botulinum achieved.
We also carry out broth studies to establish if antimicrobials may have an inhibitory effect on C.botulinum growth.
Shiga toxin-producing E. coli (STEC) – UKAS accredited testing for sprouted seeds, grains and pulses (UKAS Ref 1079)
Shiga toxin-producing E. coli (STEC) are thought to be the most potent group of pathogenic E. coli. They are a group of E. coli that possess stx genes which code for “Shiga toxin” (sometimes referred to as Verocytotoxin). There are many hundreds of STEC serogroups that exist which all have the potential to cause human illness, and E. coli O157 is the most well-known within this group.
We have a Containment Level 3 laboratory for handling STEC, and our STEC testing service is accredited by UKAS to ISO/IEC 17025:2017 under reference 1079, for the detection of STEC O26, O103, O111, O145, O157, O45 and O121 (TES-MB-225 method).
Our UKAS accredited STEC testing is available with both standard and rapid turnaround times. Furthermore, we offer valuable support in the interpretation of results, which can often present a challenge when testing for STEC.
Effective control of pathogenic microorganisms in production – we are here to help
Alongside the pathogen typing, C. botulinum inoculated studies and STEC testing discussed here, you can also contact our experts for help with the food safety assurance of your end-to-end supply chain. This includes microbiology support, product testing, hygiene consultancy, process control, decontamination methods, food safety and quality management systems, incident management, root cause analysis and more.
For existing products, product development and exploring new ingredient / product categories and Manufacturing processes, we can help with optimal risk reduction strategies.
We can advise on your testing and methodology requirements for your specific situation and product, and can conduct microbiological testing, either for routine analysis, or analysis in response to a challenge or for investigations / troubleshooting.
When it comes to hygiene and preventing contamination from the food processing / production environment, we can support with hygienic design, cleaning and environmental monitoring plans (EMP). We can visit your site to provide practical support with proactive initiatives and troubleshooting alike.
For pathogens of concern, we develop, validate and help implement effective decontamination methods into client facilities. We also support clients with process control design / review, implementation and validation – from a microbiological / decontamination perspective and more broadly.

About Suzanne Jordan
Suzanne has worked here at Campden BRI since 2005, following nine years of PhD and postdoctoral research experience in food microbiology and molecular biology of food microorganisms.
Suzanne is the lead for third party microbiological method validation studies for AOAC, MicroVal and NordVal, is a Retailer-approved Method Review Co-ordinator, and is involved in several research and contract projects for developing and evaluating new methodology. Alongside this, she is an industrial PhD supervisor for a project on the of fine-tuning dietary fibre to target gut microbiota accessibility.
During her career to date she has participated in multidisciplinary research projects involving European partners, developed expertise in a range of molecular techniques, and presented her research at an international level and in peer-reviewed journals.

About Linda Everis
Linda has a wealth of knowledge, experience and expertise from her time in Microbiological Analytical Services and Microbiology Safety and Spoilage. She joined Campden BRI in 1995 as a Senior Technician in the Microbiological Analytical Services group having graduated from the University of Wales Aberystwyth with a BSc in Biology.
Alongside the expert support that Linda provides to our members and clients, Linda conducts project work and research, and has been author and co-author of articles and papers for a variety of microbiological publications and Campden BRI reports.
Linda also lectures on shelf-life, challenge testing and predictive microbiology for our many training courses and seminars.
Food microbiology
Protect your customers and your brand from risk with our unique wrap around testing and advisory microbiology solutions.
Clostridium botulinum studies
For support with C.botulinum or related testing studies, get in touch.







